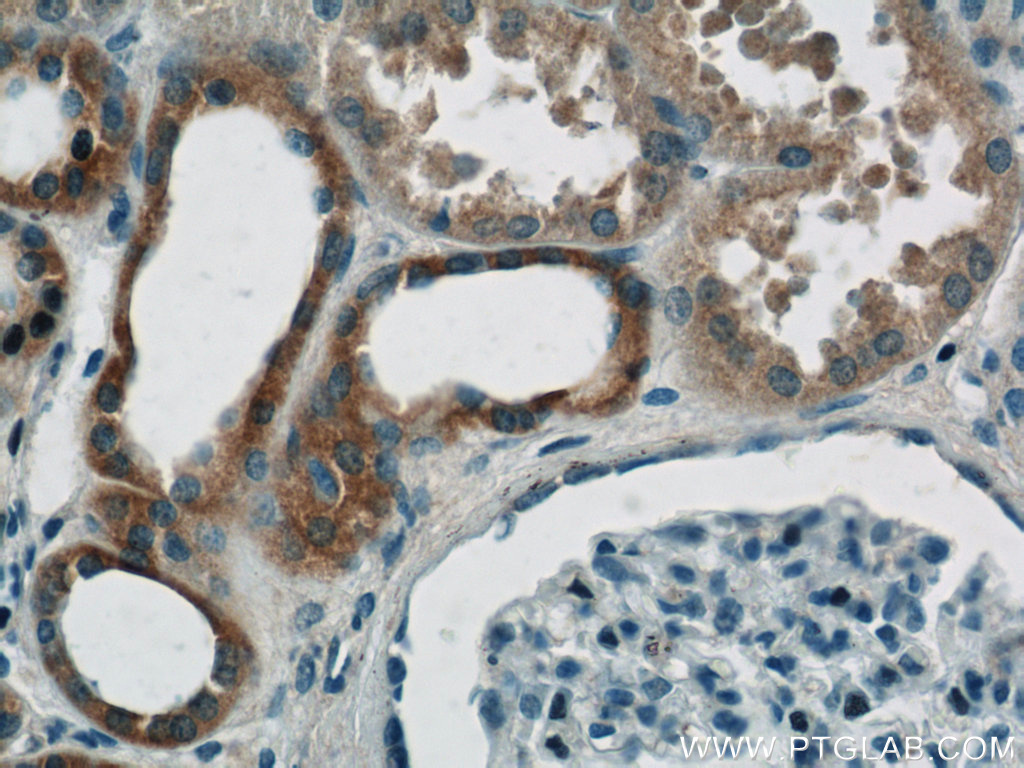

验证数据展示
经过测试的应用
| Positive WB detected in | HEK-293T cells, human kidney tissue, mouse heart tissue, L02 cells, HepG2 cells, human testis tissue, human heart tissue, K-562 cells, Hela cells |
| Positive IP detected in | L02 cells |
| Positive IHC detected in | human colon tissue, human kidney tissue, human heart tissue, human lung cancer tissue Note: suggested antigen retrieval with TE buffer pH 9.0; (*) Alternatively, antigen retrieval may be performed with citrate buffer pH 6.0 |
| Positive IF/ICC detected in | HeLa cells |
推荐稀释比
| 应用 | 推荐稀释比 |
|---|---|
| Western Blot (WB) | WB : 1:1000-1:10000 |
| Immunoprecipitation (IP) | IP : 0.5-4.0 ug for 1.0-3.0 mg of total protein lysate |
| Immunohistochemistry (IHC) | IHC : 1:50-1:500 |
| Immunofluorescence (IF)/ICC | IF/ICC : 1:50-1:500 |
| It is recommended that this reagent should be titrated in each testing system to obtain optimal results. | |
| Sample-dependent, Check data in validation data gallery. | |
产品信息
11237-1-AP targets MIRO2 in WB, IHC, IF/ICC, IP, CoIP, ELISA applications and shows reactivity with human, mouse samples.
| 经测试应用 | WB, IHC, IF/ICC, IP, ELISA Application Description |
| 文献引用应用 | WB, IHC, IF, IP, CoIP |
| 经测试反应性 | human, mouse |
| 文献引用反应性 | human, mouse, rat, monkey |
| 免疫原 |
CatNo: Ag1752 Product name: Recombinant human RHOT2 protein Source: e coli.-derived, PGEX-4T Tag: GST Domain: 319-618 aa of BC014942 Sequence: DRDGALSPVELQSLFSVFPAAPWGPELPRTVRTEAGRLPLHGYLCQWTLVTYLDVRSCLGHLGYLGYPTLCEQDQAHAITVTREKRLDQEKGQTQRSVLLCKVVGARGVGKSAFLQAFLGRGLGHQDTREQPPGYAIDTVQVNGQEKYLILCEVGTDGLLATSLDATCDVACLMFDGSDPKSFAHCASVYKHHYMDGQTPCLFVSSKADLPEGVAVSGPSPAEFCRKHRLPAPVPFSCAGPAEPSTTIFTQLATMAAFPHLVHAELHPSSFWLRGLLGVVGAAVAAVLSFSLYRVLVKSQ 种属同源性预测 |
| 宿主/亚型 | Rabbit / IgG |
| 抗体类别 | Polyclonal |
| 产品类型 | Antibody |
| 全称 | ras homolog gene family, member T2 |
| 别名 | RHOT2, MIRO 2, hMiro-2, hMiro 2, EC:3.6.5.- |
| 计算分子量 | 68 kDa |
| 观测分子量 | 80 kDa |
| GenBank蛋白编号 | BC014942 |
| 基因名称 | RHOT2 |
| Gene ID (NCBI) | 89941 |
| RRID | AB_2179539 |
| 偶联类型 | Unconjugated |
| 形式 | Liquid |
| 纯化方式 | Antigen affinity purification |
| UNIPROT ID | Q8IXI1 |
| 储存缓冲液 | PBS with 0.02% sodium azide and 50% glycerol, pH 7.3. |
| 储存条件 | Store at -20°C. Stable for one year after shipment. Aliquoting is unnecessary for -20oC storage. |
背景介绍
RHOT2 (Ras homolog gene family, member T2), also known as ARHT2, RASL or MIRO-2 (mitochondrial Rho GTPase 2), is a 618 amino acid single-pass type IV membrane protein as a member of the Rho family of GTPases. It is localized to the outer mitochondrial membrane and plays a role in mitochondrial trafficking and fusion-fission dynamics. RHOT2 is ubiquitously expressed with highest levels found in pancreas, heart, kidney and skeletal muscle. MIRO2 is highly phosphorylated at basal conditions, as evidenced by an immunoreactive band that electrophoretically migrates 7 kDa higher (~75 kDa) compared to its predicted molecular weight (68 kDa) (PMID: 28556983).
实验方案
| Product Specific Protocols | |
|---|---|
| IF protocol for MIRO2 antibody 11237-1-AP | Download protocol |
| IHC protocol for MIRO2 antibody 11237-1-AP | Download protocol |
| IP protocol for MIRO2 antibody 11237-1-AP | Download protocol |
| WB protocol for MIRO2 antibody 11237-1-AP | Download protocol |
| Standard Protocols | |
|---|---|
| Click here to view our Standard Protocols |
发表文章
| Species | Application | Title |
|---|---|---|
Cell Mis-splicing-derived neoantigens and cognate TCRs in splicing factor mutant leukemias | ||
Nat Cell Biol MIROs and DRP1 drive mitochondrial-derived vesicle biogenesis and promote quality control.
| ||
Neuron Brain-derived autophagosome profiling reveals the engulfment of nucleoid-enriched mitochondrial fragments by basal autophagy in neurons. | ||
Sci Adv Global ubiquitylation analysis of mitochondria in primary neurons identifies endogenous Parkin targets following activation of PINK1. | ||
EMBO Rep Parkin-mediated ubiquitylation redistributes MITOL/March5 from mitochondria to peroxisomes. | ||
EMBO Rep MICAL2PV suppresses the formation of tunneling nanotubes and modulates mitochondrial trafficking. |